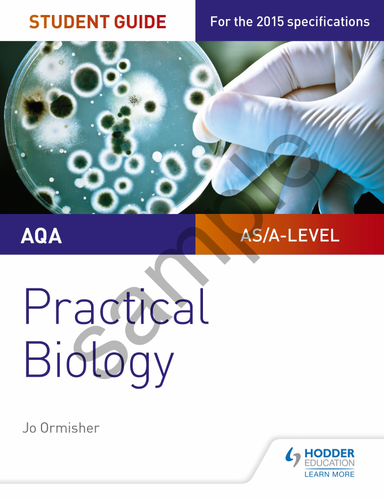
pdf, 3.69 MB

This bundle includes all FULL lessons associated with the topic biological molecules
L1 - Carbohydrates and monomers
L2 -Starch glycogen and Cellulose
L3 - Benedicts test
L4 - Benedicts pt 2
L5 - Lipids
L6 - Proteins
L7 - Buffer lesson
L8 - Induced fit model
L9 - Factors affecting enzymes
L10 - Factors affecting enzymes
L11 - Buffer lesson
L12 - Enzyme practical
L13 - Tangent drawing ( maths skill)
Something went wrong, please try again later.
This resource hasn't been reviewed yet
To ensure quality for our reviews, only customers who have purchased this resource can review it
Report this resourceto let us know if it violates our terms and conditions.
Our customer service team will review your report and will be in touch.
£5.00
